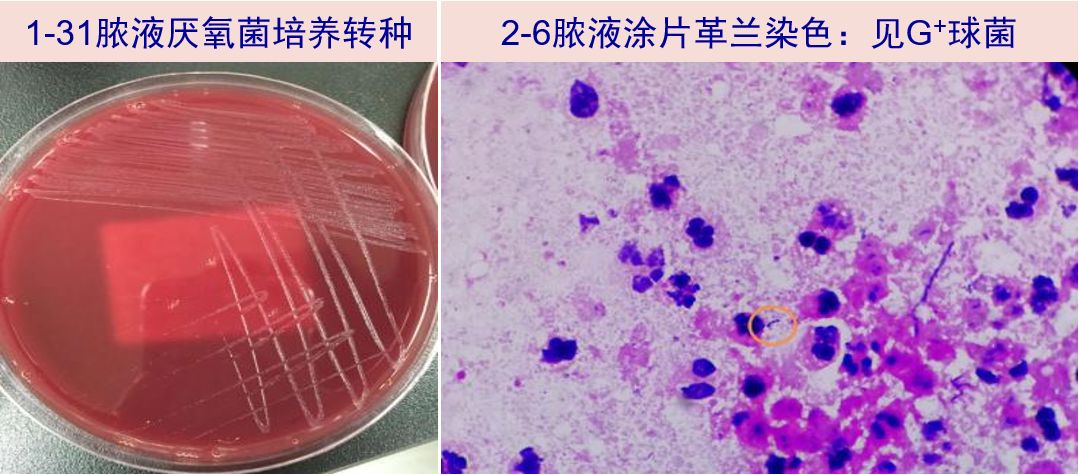
星空官方网站

联系我们 contact us
- 手机:
- 17245631280
- 电话:
- 072-57425335
- 邮箱:
- admin@guanghuidata.com
- 地址:
- 台湾省台湾市台湾区工心大楼38号
‘星空app官网’天气渐凉长袖连衣裙让你美腻到秋天
添加时间:2025-12-19
本文摘要:天气渐凉,近几天长袖都穿着一起了没有?
本文关键词:星空app官网,星空官方网站,星空app官方网页
天气渐凉,近几天长袖都穿着一起了没有?可是爱美裙的女孩子可忘了脱下长裙,来一款长袖的连衣裙,既能抵抗凉风,又省却配上的困难,让你一路美腻到秋天。慢来想到潮人们是怎么应付早秋的吧!【今日配上】一件长袖连衣裙就能精彩搞定早秋配上,不过想穿抢眼,一定要学会配上。下面再行为大家引荐几款精妙配上,让你穿入时尚感觉。

【配上Tips】Tips1:长袖雪纺连衣裙+低跟短靴天气微冷时,不妨将长袖雪纺连衣裙配上低跟短靴,短靴的材质可以青着小牛皮或是绒面,通过这样,让你造型极具质感。Tips2:长袖连衣裙+高筒靴利用一个亮色复古包和一双高筒靴子鞋帮你打造出欧式复古,但要留意这时候的连衣裙以浅色系居多,不然就和亮色挎包抢走颜色而造成杂乱感觉。

Tips3连衣裙+短款牛仔外套牛仔外套也是近几年衣橱不可或缺单品之一,配上短款牛仔外套,利用牛仔外套的结构感觉,让你身段更为立挺。

本文关键词:星空app官网,星空官方网站,星空app官方网页
本文来源:星空app官网-www.guanghuidata.com



